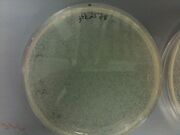

Uploads by Wei-Chun Hu
From OpenWetWare
Jump to navigationJump to search
This special page shows all uploaded files.
| Date | Name | Thumbnail | Size | Description |
|---|---|---|---|---|
| 21:47, 28 April 2010 | TECAN-spreadsheet.xls (file) | 732 KB | ||
| 21:42, 28 April 2010 | Te-5yes.png (file) |  |
14 KB | |
| 21:42, 28 April 2010 | Te-3yes.png (file) |  |
16 KB | |
| 21:42, 28 April 2010 | Te-1yes.png (file) |  |
19 KB | |
| 21:42, 28 April 2010 | Te-5no.png (file) |  |
19 KB | |
| 21:41, 28 April 2010 | Te-3no.png (file) |  |
14 KB | |
| 21:41, 28 April 2010 | Te-1no.png (file) |  |
20 KB | |
| 21:04, 28 April 2010 | Elisa-data.xls (file) | 21 KB | ||
| 22:29, 21 April 2010 | Notes-protein-purification.jpg (file) |  |
3.9 MB | |
| 22:54, 14 April 2010 | Tecansafireii-pic.jpg (file) |  |
19 KB | |
| 02:23, 14 April 2010 | Jtk2619-jtk2164-041410.jpg (file) |  |
1.08 MB | |
| 02:22, 14 April 2010 | Jtk2578-jtk2164-041410.jpg (file) | |
1.07 MB | |
| 02:21, 14 April 2010 | Jtk2559-jtk2164-041410.jpg (file) |  |
1.11 MB | |
| 20:47, 31 March 2010 | PMLL4-AC.ape (file) | 6 KB | ||
| 01:39, 16 March 2010 | WJH plates 031510.jpg (file) |  |
68 KB | |
| 23:16, 15 March 2010 | WJH gels 031510.jpg (file) |  |
60 KB | |
| 00:24, 25 February 2010 | MN022410.png (file) |  |
210 KB | |
| 00:07, 25 February 2010 | AStwo22410.png (file) |  |
237 KB | Prep Gel 2 |
| 23:55, 24 February 2010 | AS22410.png (file) |  |
138 KB | Prep Gel |
| 22:57, 24 February 2010 | JH022410gelprep.jpg (file) |  |
139 KB | |
| 22:46, 24 February 2010 | JC022410gelprel.jpg (file) |  |
306 KB | |
| 23:10, 16 February 2010 | 2-17-10-cloning-PCR.pdf (file) | 178 KB | ||
| 00:41, 4 February 2010 | Weichunhsu.jpg (file) |  |
372 KB |